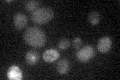
YLR368W

View description
F-box protein; associates with mitochondria and has a role in mitochondrial fusion; stimulates nuclear export of specific mRNAs; promotes ubiquitin-mediated degradation of Gal4p in some strains
Localization:
Intensity:
Fold change:
Significance:
-
C’ GFP library in SD

below threshold13.29 -
N' NOP1pr-GFP in SD

cytosol,nucleus42.1094 -
N' TEF2pr-mCherry in SD

nucleus45.9719 -
N' NATIVEpr-GFP in SD

below threshold20.5563 -
N' TEF2pr-VC and Cyto-VN in SD

cytosol,punctate32.0942 -
C’ GFP library in SD+DTT

cytosol16.981.27No -
C’ GFP library in SD+H2O2

cytosol13.71.03No -
C’ GFP library in Starvation Media
cytosol19.691.48No -
C’ GFP library on the background of Pup2-DaMP

below threshold -
C’ GFP library on the background of CCT mutant

below threshold16.81751.26469No
